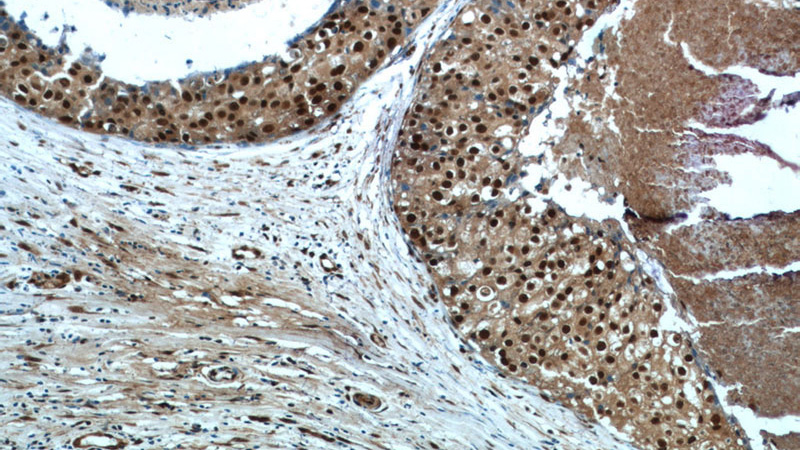
Immunohistochemistry of paraffin-embedded human breast cancer tissue slide using Catalog No:115662(SRA1 Antibody) at dilution of 1:50 (under 10x lens)
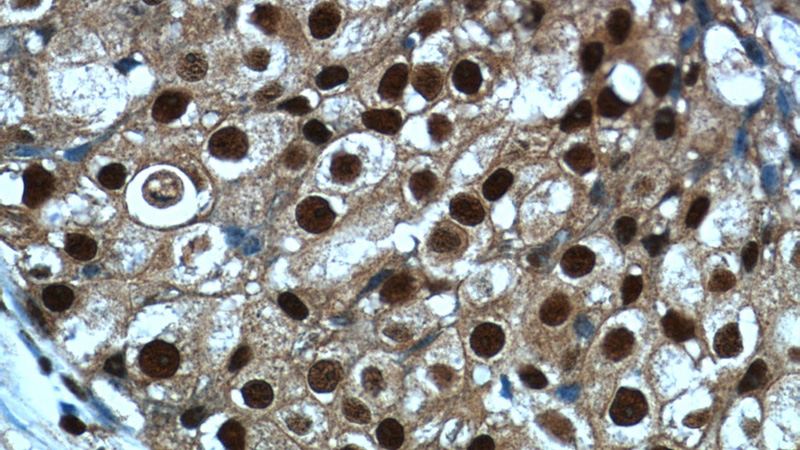
Immunohistochemistry of paraffin-embedded human breast cancer tissue slide using Catalog No:115662(SRA1 Antibody) at dilution of 1:50 (under 40x lens)

-
Product Name
SRA1 antibody
- Documents
-
Description
SRA1 Rabbit Polyclonal antibody. Positive WB detected in MCF-7 cells, A2780 cells, HEK-293 cells. Positive IHC detected in human breast cancer tissue. Positive FC detected in MCF-7 cells. Observed molecular weight by Western-blot: 30 kDa, 33 kDa
-
Tested applications
ELISA, WB, IHC, FC
-
Species reactivity
Human; other species not tested.
-
Alternative names
pp7684 antibody; SRA antibody; SRA1 antibody; SRAP antibody; STRAA1 antibody
-
Isotype
Rabbit IgG
-
Preparation
This antibody was obtained by immunization of SRA1 recombinant protein (Accession Number: BC067895). Purification method: Antigen affinity purified.
-
Clonality
Polyclonal
-
Formulation
PBS with 0.1% sodium azide and 50% glycerol pH 7.3.
-
Storage instructions
Store at -20℃. DO NOT ALIQUOT
-
Applications
Recommended Dilution:
WB: 1:500-1:5000
IHC: 1:20-1:200
-
Validations

MCF-7 cells were subjected to SDS PAGE followed by western blot with Catalog No:115662(SRA1 Antibody) at dilution of 1:1000
Immunohistochemistry of paraffin-embedded human breast cancer tissue slide using Catalog No:115662(SRA1 Antibody) at dilution of 1:50 (under 10x lens)
Immunohistochemistry of paraffin-embedded human breast cancer tissue slide using Catalog No:115662(SRA1 Antibody) at dilution of 1:50 (under 40x lens)

1X10^6 MCF-7 cells were stained with 0.2ug SRA1 antibody (Catalog No:115662, red) and control antibody (blue). Fixed with 4% PFA blocked with 3% BSA (30 min). Alexa Fluor 488-congugated AffiniPure Goat Anti-Rabbit IgG(H+L) with dilution 1:1500.
-
Background
Steroid receptor RNA activator 1 (SRA1), also known as seroid receptor RNA activator protein (SRAP) or SRA, is involved in modulating the activity of multiple transcription factors including the estrogen receptor (ER) (PMID: 20398657). It may play a role in tumorigenesis (PMID: 16152589). The SRA1 gene encodes both SRA1 protein and a non-coding functional RNA that functions as part of a ribonucleoprotein complex activating steroid receptor induced transcription. This polyclonal antibody recognizes endogenous SRA1 isoforms which migrate as a doublet on SDS-PAGE gels (PMID: 12565891; 23907597).
-
References
- Hu YW, Ma X, Huang JL. Dihydrocapsaicin Attenuates Plaque Formation through a PPARγ/LXRα Pathway in apoE(-/-) Mice Fed a High-Fat/High-Cholesterol Diet. PloS one. 8(6):e66876. 2013.
- Hu YW, Yang JY, Ma X. A lincRNA-DYNLRB2-2/GPR119/GLP-1R/ABCA1-dependent signal transduction pathway is essential for the regulation of cholesterol homeostasis. Journal of lipid research. 55(4):681-97. 2014.
- Hu YW, Zhao JY, Li SF. RP5-833A20.1/miR-382-5p/NFIA-dependent signal transduction pathway contributes to the regulation of cholesterol homeostasis and inflammatory reaction. Arteriosclerosis, thrombosis, and vascular biology. 35(1):87-101. 2015.
Related Products / Services
Please note: All products are "FOR RESEARCH USE ONLY AND ARE NOT INTENDED FOR DIAGNOSTIC OR THERAPEUTIC USE"
